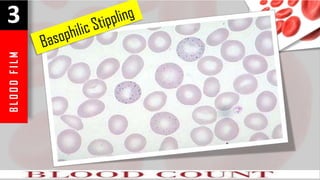
B
L
O
O
D
F
I
L
M
3

The document provides a comprehensive overview of blood components, including red blood cells (RBCs), white blood cells (WBCs), hemoglobin, hematocrit, and platelet counts, including their normal ranges and implications for anemia diagnosis. It details approaches to different types of anemia based on RBC counts, hemoglobin levels, and additional lab results, distinguishing between microcytic, normocytic, and macrocytic anemias. The document also covers various blood disorders, diagnostic tests, and the significance of reticulocyte counts in assessing anemia causes.